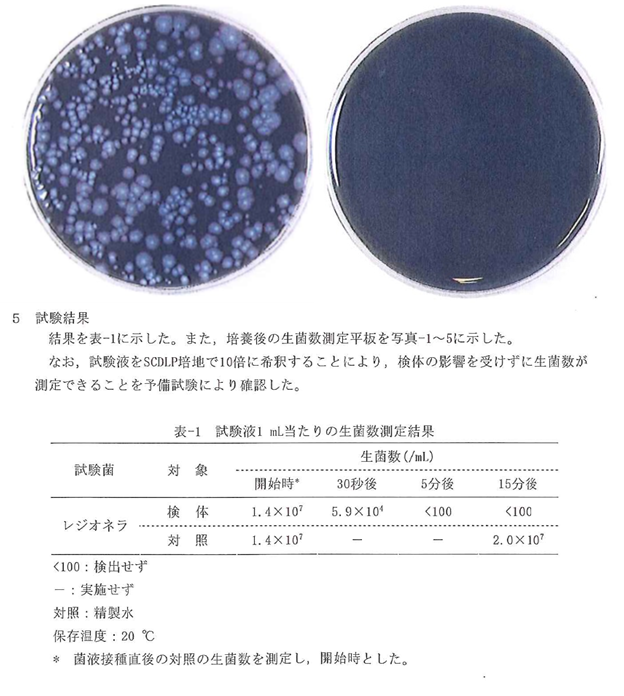

「あるかりん」不活化試験結果ーノロウィルス
日本食品分析センターによるノロウィルス不活化試験においてあるかりんの効果が証明されております。


「あるかりん」不活化試験結果ー大腸菌
日本食品分析センターによる大腸菌殺菌効果試験において、あるかりんの効果が証明されております。



「あるかりん」不活化試験結果ーレジオネラ菌
日本食品分析センターによるレジオネラ菌の不活化試験において、あるかりんの効果が証明されております。